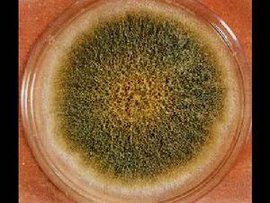
黃麴黴

介紹
顯微鏡下的黃麴黴菌落上世紀60年代,在英國發生的十萬隻火雞突發性死亡事件被確認與從巴西進口的花生粕有關。進一步的調研證明,這些花生粕被一種來自真菌的有毒物質污染,這些研究工作最終使人們發現了黃麴黴(aspergillus。flavus)產生的有毒代謝物質,黃麴黴毒素(aflatoxins)是黃麴黴和寄生麴黴的代謝產物,特麴黴也能產生黃麴黴毒素,但產量較少。產生的黃麴黴毒素主要有b1,b2,g1,g2以及另外兩種代謝產物m1,m2。其中m1和m2是從牛奶中分離出來的。b1,b2,g1,g2,m1和m2的在分子結構上十分接近。
黃麴黴的有些菌系能產生黃麴黴毒素,不僅能引起禽畜中毒致死,亦有致癌作用。
化學結構
黃麴黴毒素(aflatoxins),是一組化學結構類似的化合物,已分離鑑定出12種,包括b1,b2,g1,g2,m1,m2,p1,q,h1,gm,b2a和毒醇。黃麴黴毒素的的基本結構為二呋喃環和香豆素,b1是二氫呋喃氧雜萘鄰酮的衍生物。即含有一個雙呋喃環和一個氧雜萘鄰酮(香豆素)。前者為基本毒性結構,後者與致癌有關。m1是黃麴黴毒素b1在體內經過羥化而衍生成的代謝產物。黃麴黴毒素的主要分子型式含b1,b2,g1,g2,m1,m2等。其中m1和m2主要存在於牛奶中。b1為毒性及致癌性最強的物質。
理化特
性
在紫外線下,黃麴黴毒素b1,b2發藍色螢光,黃麴黴毒素g1,g2發綠色螢光。黃麴黴毒素的相對分子量為312-346。難溶於水,易溶於油,甲醇,丙酮和氯仿等有機溶劑,但不溶於石油醚,己烷和乙醚中。一般在中性溶液中較穩定,但在強酸性溶液中稍有分解,在ph9-10的強鹼溶液中分解迅速。其純品為無色結晶,耐高溫,黃麴黴毒素b1的分解溫度為268℃紫外線對低濃度黃麴黴毒素有一定的破壞性。
分布
黃麴黴毒素存在於土壤,動植物,各種堅果,特別是花生和核桃中。在玉米,通心粉,調味品牛奶,奶製品,食用油等製品中也經常發現黃麴黴毒素。一般在熱帶和亞熱帶地區,食品中黃麴黴毒素的檢出率比較高,在中國,產生黃麴黴毒素的產毒菌種主要為黃麴黴,1980年測定了從17個省糧食中分離的黃麴黴1660株,廣西地區的產毒黃麴黴最多,檢出率為58%。總的分布情況為:華中,華南,華北產毒株多,產毒量也大,東北,西北地區較少。
中毒危害
黃麴黴毒素對人和動物健康的危害均與黃麴黴毒素抑制蛋白質的合成有關。黃麴黴毒素分子中的雙呋喃環結構,是產生毒性的重要結構。研究表明,黃麴黴毒素的細胞毒作用,是干擾信息rna和dna的合成,進而干擾細胞蛋白質的合成,導致動物全身性損害(nibbelink,1988)。黃光琪等(1993)研究指出,黃麴黴毒素b1能與trna結合形成加成物,黃麴黴毒素-trna加成物能抑制trna與某些胺基酸結合的活性,對蛋白質生物合成中的必需胺基酸,如賴氨酸,亮氨酸,精氨酸和甘氨酸與trna的結合,均有不同的抑制作用,從而在翻譯水平上干擾了蛋白質生物合成,影響細胞代謝。。
對動物
黃麴黴毒素中毒(aflatoxicosis)主要對動物肝臟的傷害,受傷害的個體因動物種類,年齡,性別和營養狀態而異。研究結果表明,黃麴黴毒素可導致肝功能下降,降低牛奶產量和產蛋率。並使動物的免疫力降低,易受有害微生物的感染。此外,長期食用含低濃度黃麴黴毒素的飼料也可導致胚胎內中毒。通常年幼的動物對黃麴黴毒素更敏感。黃麴黴毒素的臨床表現為消化系統功能紊亂,降低生育能力。降低飼料利用率,貧血等。黃麴黴毒素不僅能夠使奶牛的產奶量下降,而且還使牛奶中含有轉型的黃麴黴毒素m1和m2。據美國農業經濟學家統計,由於食用黃麴黴毒素污染的飼料,每年至少要使美國畜牧業遭受10%的經濟損失。在中國,由此而帶來的畜牧業損失可能會更大。
對人體
黃麴黴黃麴黴毒素bl的半數致死量為0。36毫克/公斤體重,屬特劇毒的毒物範圍(動物半數致死量<10毫克/公斤=它的毒性比氰化鉀大10倍,比砒霜大68倍)。它引起人的中毒主要是損害肝臟,發生肝炎,肝硬化,肝壞死等。臨床表現有胃部不適,食慾減退,噁心,嘔吐,腹脹及肝區觸痛等;嚴重者出現水腫,昏迷,以至抽搐而死。黃麴黴毒素是目前發現的最強的致癌物質。其致癌力是奶油黃的900倍,比二甲基亞硝胺誘發肝癌的能力大75倍,比3,4苯並芘大4000倍。它主要誘使動物發生肝癌,也能誘發胃癌,腎癌,直腸癌及乳腺,卵巢,小腸等部位的癌症。
檢驗檢疫要求
1995年,世界衛生組織制定的食品黃麴黴毒素最高允許濃度為15ug/kg。
美國聯邦政府有關法律規定人類消費食品和奶牛飼料中的黃麴黴毒含量(指b1+b2+g1+g2的總量)不能超過15ug/kg。人類消費的牛奶中的含量不能超過0。5ug/kg,其他動物飼料中的含量不能300ug/kg。
而歐盟國家規定更加嚴格,要求人類生活消費品中的黃麴黴毒素b1的含量不能超過0。05ug/kg。
檢驗檢疫方法
薄層層析
薄層層析(thin-layerchromatography,tlc)是在黃麴黴毒素研究方面套用最廣的分離技術。自1990年,它被列為aoac(associationofofficialagriculturalchemists)標準方法,該方法同時具有定性和定量分析黃麴黴毒素的功能。
液相色譜
液相色譜(liquidchromatography,lc)與薄層層析在許多方面具有相似性,二者互相補充。通常用tlc進行前期的條件設定,選擇適宜的分離條件後,再用lc進行黃麴黴毒素的定量測定。
免疫化學分析
黃麴黴(1)免疫親和柱-螢光分光光度法和免疫親和術-hplc法免疫親和柱法和酶聯免疫吸附法雖然都可達到速簡便效果,但酶聯免疫吸附法僅能檢測單一毒素(如黃麴黴毒素b1)含量,而且易出現假陽性結果,難以控制。免疫親和柱法(包括螢光光度法和hplc法)卻能達到既定量準確又快速簡便的要求。
免疫親和柱的使用可以避免傳統tlc和hplc的缺點,同時免疫親和柱與tlc和hplc法結合可以大大提高工作效率,提高靈敏度和準確度。
黃麴黴毒素免疫親和柱-螢光光度計法是以單克隆免疫親和柱為分離手段,用螢光計,紫外燈作為檢測工具的快速分析方法。它克服了tlc和hplc法在操作過程中使用劇毒的真菌毒素作為標定標準物和在樣品預處理過程中使用多種有毒,異味的有機溶劑,毒害操作人員和污染環境的缺點。同時黃麴黴毒素免疫親和柱-螢光光度計法分析速度快,一個樣品只需10-15min,比傳統方法快幾個小時甚至幾天時間;儀器設備輕便容易攜帶,自動化程度高,操作簡單,直接讀出測試結果,可以在小型實驗或現場使用。可以進行黃麴黴毒素總量(b1b2g1g2)的測定,檢測限可達到1ug/kg,達到黃麴黴毒素標準限量值以下測定範圍為1-300ug/kg。
黃麴黴毒素免疫親和柱-高效液相色譜法比傳統的hplc法更加安全,可靠,靈敏度和準確度高。它採用單克隆抗體免疫技術,可以特效性地將黃麴黴毒素或其他真菌毒素分離出來,分離效率和回收率高。
分析原理試樣中的黃麴黴毒素用一定比例的甲醇/水提取液經過過濾,稀釋後,用免疫親和柱淨化,以甲醇將親和柱上的黃麴黴毒素淋洗下來,在淋洗液中加入溴溶液衍生,以提高測定靈敏度,然後用螢光分光光度計進行定量。也可以將甲醇-黃麴黴毒素淋洗液的一部分注入hplc中,對黃麴黴毒素b1,b2,g1,b2分別進行定量分析。免疫親和柱是用大劑量的黃麴黴毒素單克隆抗體固化在水不溶性的載體上,然後裝柱而成。該方法的測定範圍0-300ug/kg。
(2)酶聯免疫吸附法
1996年,nakane建立了辣根過氧化物酶標記抗體的測定技術。由於該方法簡便,敏感,特異,可作為多種抗原或抗體的測定,20世紀70年代後期,該方法引入真菌毒素的檢測中,下面介紹的是競爭性酶聯免疫吸附間接法檢測黃麴黴毒素b1。
原理:將已知抗原吸附在固態載體表面,洗除末吸附抗原,加入一定量抗體與待測樣品(含有抗原)提取液的混合液,競爭培養後,在固相載體表面形成抗原抗體複合物。洗除多餘抗體成分,然後加入酶標記的抗球蛋白的第二抗體結合物,與吸附在固體表面的抗原抗體結合物相結合,再加入酶底物。在酶的催化作用下,底物發生降解反應,產生有色物質,通過酶標檢測儀測出酶底物的降解量,從而推知被測樣品中的抗原量。
(3)微柱篩選法可以用來半定量測定各種食品中黃麴黴毒素b1,b2,g1,g2的總量
原理樣品提取液中的黃麴黴毒素被微柱管風矽鎂型吸附層吸附後,在波長365nm紫外光燈下顯示藍紫色螢光環,其螢光強度與黃麴黴毒素在一定的光密度範圍內成正比例關係。若矽鎂型吸附劑層未出現藍紫色螢光,則樣品為陰性(方法靈敏度為5-10ug/kg)。由於在微柱上不能分離黃麴黴毒素b1,b2,g1,g2,所以測得結果為總的黃麴黴毒素含量。
(4)一步式黃麴黴毒素檢測金標試紙法
一步式黃麴黴毒素檢測金標試紙法是利用單克隆抗體而設計的固相免疫分析法。由此產生的一步式黃麴黴毒素快速檢測試紙可在5—10分鐘完成對樣品中黃麴黴毒素的定性測定。藉助黃麴黴毒素標準樣品,這種方法能估算黃麴黴毒素的含量,非常適用於現場測試和進行大量樣品的初選。
檢測方法分析
薄膜層析法和液相色譜法是目前國內絕大多數檢測機構都在使用的方法,由於其檢測周期長,程式複雜,所需試劑繁多等缺點已遠遠不能滿足現代檢測要求。隨著現代科學技術的不斷發展,特別是免疫學,生物化學,分子生物學的不斷發展,人們已創建了不少快速,簡便,特異,敏感,低耗且適用的黃麴黴毒素檢測方法。而且以金標試紙為代表的這些方法已經被先進國家所廣泛使用,引進和消化這些先進的方法是我們檢測領域的當務之急。免疫親和柱法優點很多,但由於檢測費用過高,而無法普及。而一步式黃麴黴毒素檢測金標試紙法似乎更適用於中國,值得推廣。
菌物界(一)
| “菌物界”這個名詞是我國學者裘維蕃等於1990年提出的,並已得學術界的一定支持,這是指與動物界,植物界相併列的一大群無葉綠素,依靠細胞表面吸收有機養料,細胞壁一般還有幾丁質的真核微生物。一般包括真菌,粘菌和假菌(卵菌等)3類。 |